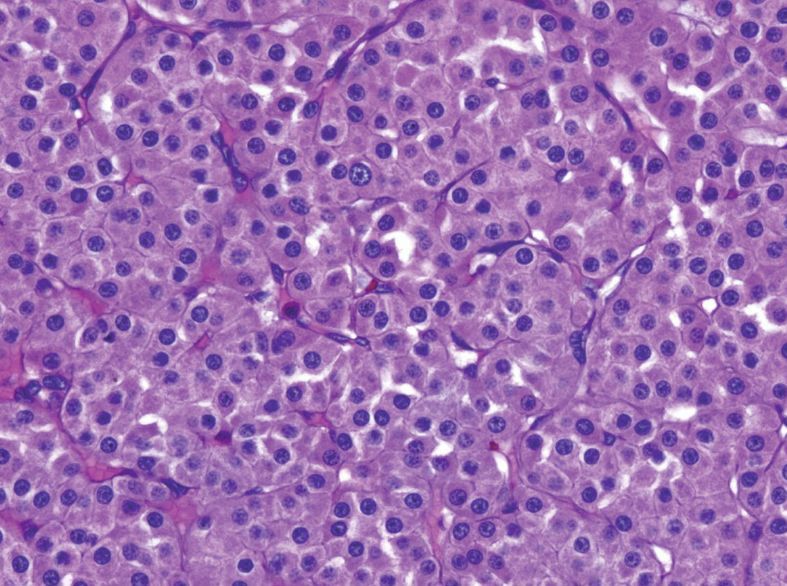
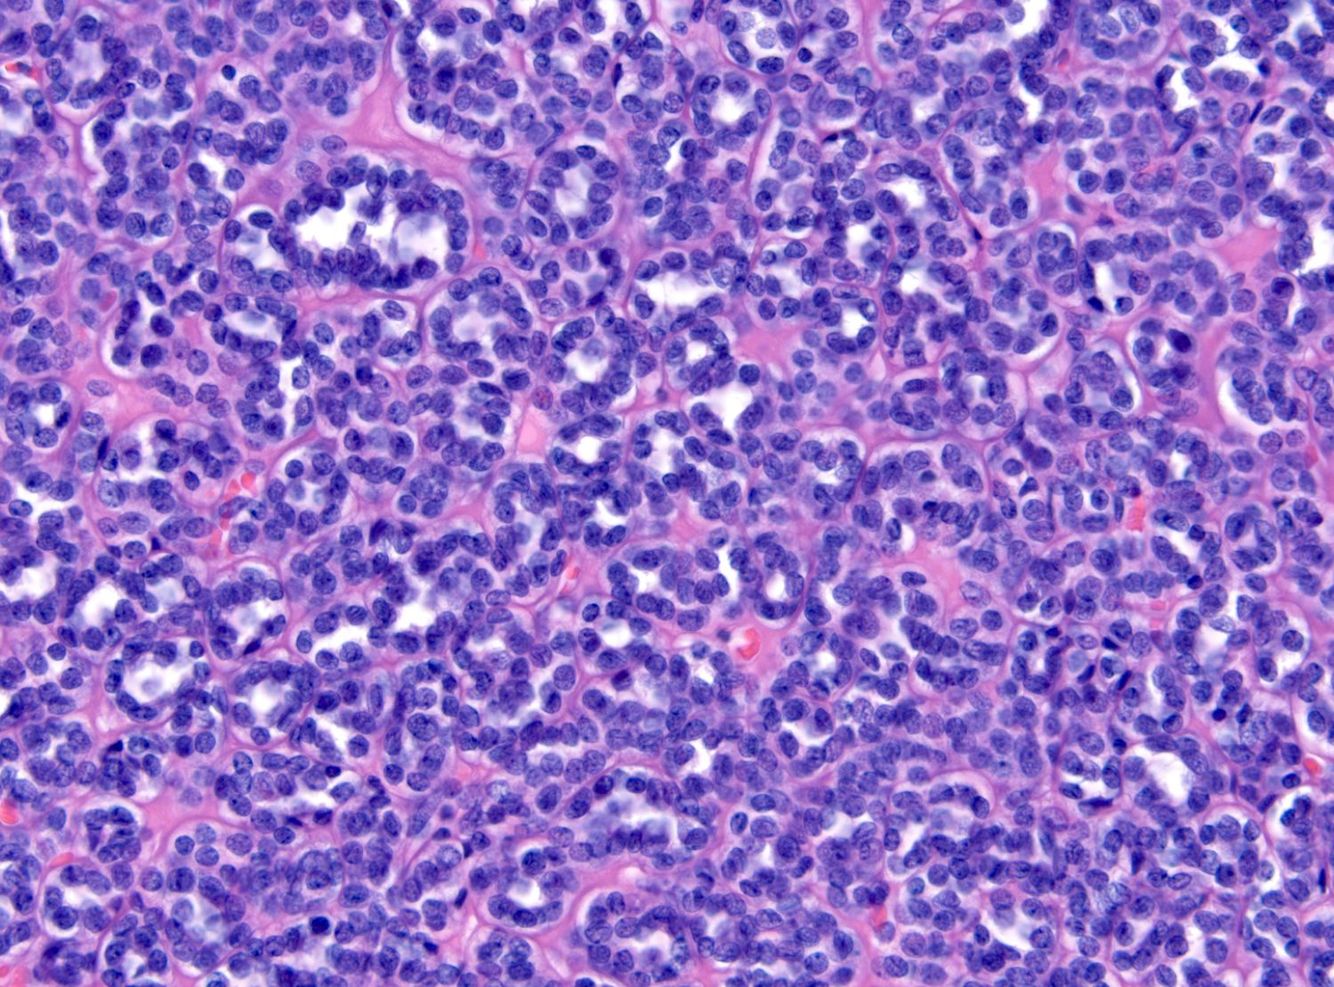

Key prognostic factors for kidney cancer identified on gross anatomy

Simple renal cyst
Very common.
Dilated tubule with a low cuboidal or flattened pink epithelial lining. Usually unilocular. If multilocular, septa divind the cysts should be unremarkaable stroma with no epithelial islands or nodules.
There should be no clear cells.

Cystic nephroma / multilocular cyst
In adults, “cystic nephroma” means “one of those ectopic-ovarian-stroma-lesions mainly found in women.” It is related to the mixed epithelial and stromal tumor (MEST).
A multilocular cyst with background ovarian-type stroma. Estrogen and progesterone receptor positive. Cyst lining is cuboidal to hobnailed.
There should be no clear cells.

Clear cell renal cell carcinoma
Can present as a cyst in serveral ways: Arising from the wall of a simple cyst, a solid tumor mass that can undergo cystic degeneration, or purely within the cyst lining of a multilocular cyst.
On gross anatomy, clear cell appears as a granular, golden-yellow-orange, well-circumscribed tumor with a color and texture similar to normal adrenal cortex.
The main indicator in all cases is the presence of clear cell aggregates or nests within cyst walls or septae. A net-like array of delicate capillaries is often present.

Multilocular cystic renal neoplasm of low malignant potential
Recognized sub-type of clear cell RCC. The cyst lining and fibrovascular sepeta are composed of clear cells with small dark nuclei.
Has an extremely indolent pattern of behavior.

Angiomyolipoma
Benign tmor characterized by:
Tumor of the perivascular epithelioid cell tumor (PEComa) family, all of which stain for all melanoma markers except S100.

Mixed epithelial and stromal tumor (MEST)
In short, the renal version of a fibroadenoma. A benign mixture of stromal and epithelial elements. Sometimes cystic.
Histologically includes a population of cytologically benign tubules of varying shapes and sizes in a background of bland spindly stroma.
Also ER and PR positive, like adult cystic nephroma.
1 rookie mistake in renal pathology
Calling normal adrenal cortex a renal cell clear cell carcinoma
Adrenal cortical cells should have visible vacuoles that indent the nucleus, giving it a stellate outline.

IUSP grading of clear cell RCC


Chromophobe renal cell carcinoma
Pale pink under the microscope with a perinuclear clearing. May be a “feathery” pink or an oncocytic pink. It is not encapsulated and grows as a solid or papillary mass. Cell membranes are distinct and there may be occasional binucleated cells.

Clear cell papillary renal cell carcinoma
Low-grade clear cell neoplasm with a papillary or tubular architecture. Features include clear cells with small, dense, dark nuclei, cells arrarnged on delicate fibrovascular cores or packed into tight tubules, and may show cystic degeneration. Tumors are often small and well-circumscribed or encapsulated.

Mucinous tubular and spindle cell carcinoma
May or may not really be mucinous. Overall the tumor is pale and bland, sometimes with extracellular mucin.
The architecture is that of arrays of narrow tubules. It is made up of clear pale cells with indistinct cell boundaries that may fuse into spindle cell areas. Nuclei are small, round, pale, and sometimes with pinpoint nucleoli.
MiT family transcription factors
Includes TFE3, TFEB, and MiTF, among others.
A family of renal cell carcinomas arise from translocations involving these genes, including the t(6;11) RCC and the Xp11 RCC.

Xp11 translocation renal cell carcinoma
Genetically involves a fusion protein including TFE3 and one of multiple partners.
Typically a tumor with plump, clear cells, large nuclei, papillary architecture, and psammoma bodies
A member of the MiT family translocation RCCs.

t(6;11) renal cell carcinoma
Unique in its dual cell population: Nests of large clear or granular pink cells interspersed with aggregates of small compact cells that may be mistaken for lymphocytes at low power.
Oddly, this carcinoma stains positive for HMB-45, Melan-A, but not keratin or S100, which can lead to confusion for an epithelioid myelolipoma.
A member of the MiT family translocation RCCs.
Renal oncocytoma
Benign tumor resembling oncocytes (or Hurthle cells) in other organs. Grossly, it is mahogany brown and well-circumscribed, but not encapsulated. There may be a stellate scar.
The cells are round with dense, pink cytoplasm and very regular, round nuclei. Oncocytomas are not graded.
Features incompatible with diagnosis include mitoses, papillary architecture, clear cells, and grossly defined vascular invasion.
Generally speaking, a stellate scar represents. . .
. . . a nonspecific sign of slow growth

Papillary renal cell carcinoma
Cellular tumor of pink-to-blue cells that may be arranged in papillary formation, solid sheets, or trabecular cords.
The classic histologic pattern is that of a fibrovascular core packed with foamy macrophages and lined by cuboidal cells with round nuclei. This image is pathognomonic. Psamomma bodies, hemosiderin-laden macrophages, and focal clear cells may also be seen.
Tumors are divided into Type 1 (low nuclear grade) and Type 2 (high nuclear grade).

Tubulocystic renal cell carcinoma
Tumor consisting of a spongy collection of dilated tubules lined by plump, pink, apocrine-looking cells with round nuclei. Best described as “a spongy collection of dilated tubules lined by fat pink apocrine cells.”
Described as a “softy, creamy mass” on gross pathology.


Collecting Duct Carcinoma
A high-grade tumor that arises from the renal medulla. It looks and acts like an adenocarcinoma. The cytology is clearly malignant and there is a strong desmoplatic response. It may stain for mucin and CEA.
A special variant, medullary carcinoma, is found in patients with sickle cell trait.


Acquired cystic kidney disease-associated renal cell carcinoma
Found in end-stage kidneys. An unmistakable grungy mix of oncocytic cells and bubbly, microcystic architecture with hemorrhage, necrosis, and oxalate crystals.
The abundant oxalate crystals are a dead giveaway, if nothing else clues you in.

Metanephric adenoma
One of the two main “blue cell” lesions of the kidney (the other being Wilm’s tumor). Thankfully, this one is benign. In fact, it may be effectively a Wilm’s tumor that differentiated/matured.
Usually a 1x diagnosis. It is circumscribed but non-encapsulated tumor of monotonous, small, tightly-packed, dense blue cells with little or no cytoplasm.
The pattern ranges from tiny tubules to serpiginous gland-like structures.

Wilm’s tumor, aka Nephroblastoma
Generally a pediatric tumor associated with WT1 or WT2 mutations. Syndromes include Denys-Drash syndrome (WT1 mutation), Beckwith-Wiedemann syndrome (WT2), and Frasier syndrome (WT1 heterozygosity).
Should be encapsulated. May become quite large. Histology is defined as “favorable” or “unfavorable” based on presence or absence of anaplasia. Foci of anaplsia requires re-sampling.
Histology is characteried by small, blue cells (one of the “blue cell” renal tumors) with three components: epithelium forming primitive tubules, stroma, and blastema (most primitive and undifferentiated component)

Acute humoral kidney transplant rejection
Characterized by glomerulitis, tubular injury, margination of neutrophils, and C4d staining in the peritubular capillaries are characteristic.
Will typically happen within only a short period of time following transplant.